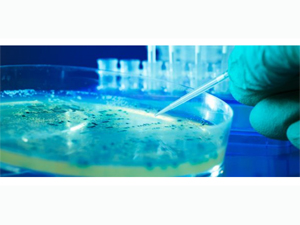
Xərçəng şişini məhv edən nanorobotlar yaradılıb, Elm və Təhsil Nazirliyi, Elm ve Tehsil Nazirliyi, Azərbaycan Respublikası Elm və Təhsil Nazirliyi, Azerbaycan Respublikasi Elm ve Tehsil Nazirliyi, Elm və Ali Təhsil üzrə Dövlət Agentliyi, Elm və Ali Təhsil, AMEA, Azərbaycan Milli Elmlər Akademiyası, Elmler Akademiyasi, İnformasiya Texnologiyaları İnstitutu, İnformasiya Texnologiyaları, AMEA ITI, AMEA İTİ, İTİ, ITI, ikt.az, ict.az, ict, ikt, www.ict.az, www.ikt.az, Rasim Aliguliyev, Rasim Əliquliyev, RM Əliquliyev, Əliquliyev Rasim, Academician Rasim Aliguliyev

ŞRİFTİN ÖLÇÜSÜ
A
A
A
ŞRİFTİN NÖVÜ
San serif
Serif
ŞƏKİLLƏRİN TƏSVİRİ
RƏNGİN TƏSVİRİ



146484649914683081191471506621.jpg?v=1772354089)